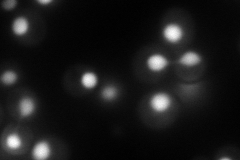
YOR252W
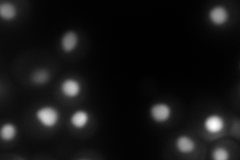
YOR252W
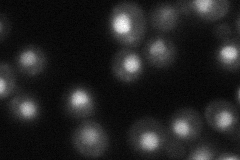
YOR252W
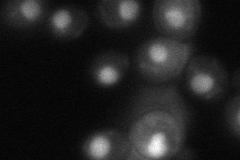
YOR252W

View description
Protein of unknown function that associates with ribosomes
Localization:
Intensity:
Fold change:
Significance:
-
C’ GFP library in SD

nucleus43.38 -
N' NOP1pr-GFP in SD
nucleus165.748 -
N' TEF2pr-mCherry in SD
nucleus211.97 -
N' NATIVEpr-GFP in SD
nucleus52.8179 -
N' TEF2pr-VC and Cyto-VN in SD
nucleus54.6348 -
C’ GFP library in SD+DTT

nucleus33.920.78No -
C’ GFP library in SD+H2O2

nucleus36.910.85No -
C’ GFP library in Starvation Media

nucleus23.30.53Yes -
C’ GFP library on the background of Pup2-DaMP

nucleus -
C’ GFP library on the background of CCT mutant

nucleus36.58420.843126No
